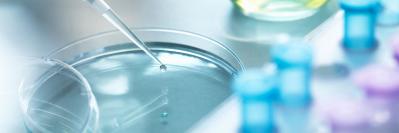
petri dish with pipette

New discoveries and a platform to develop them into products are the lifeblood of the biotechnology industry. As technology advances, opportunities for collaboration continue to drive development of DNA-based and other biological and cell-based products. But the journey to the marketplace is fraught with risk.
Saul Ewing’s attorneys have deep experience counseling biotech clients through these risks. Members of our Life Sciences team have extensive scientific depth – many in the group have PhDs – and use their understanding of the innovations to protect them in a creative manner.
Attorneys from the firm’s corporate team guide companies through the legal aspects of their growth by counseling them on partnering, mergers, acquisitions and other transactions. The team also includes labor and employment attorneys who have developed restrictive covenant agreements, including non-compete and non-disclosure agreements and employment contracts to help companies balance their interests with those who help them innovate so that they can go to market with new products. Our attorneys with experience in the health care industry have experience counseling clients on compliance with the Sunshine Act and the firm’s white collar crime and government enforcement attorneys are ready to represent them should they face an investigation, civil enforcement action or prosecution under the Food, Drug and Cosmetics Act or the False Claims Act. The team also has litigated – and settled – product liability cases and other types of claims involving life sciences industry products and companies.
Saul Ewing’s Life Sciences team has experience advising biotechnology companies working in an extensive number of fields including:
- Immunotherapy
- Cell therapy
- Vaccines
- Stem cells



